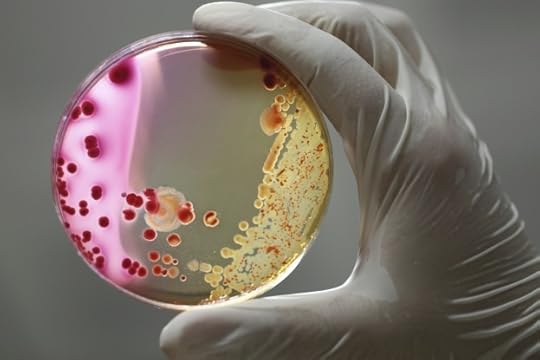
bacteria in a petri dish

Sarah Ettritch's Blog, page 4
August 17, 2016
Leap of Faith is Available
The seventh installment in the Daros Chronicles (Leap of Faith) is now available at all the usual places. This installment concludes Volume One of the Chronicles. I’ve decided to write Volume Two in one shot, rather than in installments. My goal is to release it sometime in the first half of 2017. Right now, the only reason the book might be delayed is if my editor is booked up. I’ll schedule a date with her when I’m close to finishing the first draft, which should be by the end of this year.
I’d mentioned that I’ll be doing what I did with the Rymellan Series: pulling all the existing installments together into one book. I’m still planning to do that, but I’m going to release both volumes at the same time. That means the book that contains the first seven installments won’t be available until next year.
Here’s the information for Leap of Faith:

Leap of Faith
Author: Sarah Ettritch
Series: The Daros Chronicles, Book 7
Genre: Fantasy
Fi continues searching for Erryn, but her group runs into trouble. Erryn finally reaches Loring. Is there a temple? Does she find out why she’s a Beast Master? Does she survive? More info →






In other news, I’m currently working on a standalone science fiction story that will either be a long novella, or a short novel. It’s going well, and I expect to finish the first draft by the end of September, at which point I’ll start Daros Volume Two. I’ve recently doubled (sometimes tripled) the amount of words I write each day, so completing both first drafts by the end of this year is doable. In fact, it’s more than doable. It will probably happen.
I’m intending to start the Deiform Fellowship Five in January. I was planning to start it this summer, but the science fiction story grabbed me. However, because of my increased daily word count, starting it in January will result in it being released when I’d always hoped to release it, which will be toward the end of 2017.
I’ve got other stories coming down the pipe. Now that I’m writing more words each day (because I’m dedicating more time to writing each day), I expect to release several novel-length works next year, along with shorter works.
Anyway, I hope you’ve been having a great summer. I’ll be back soon with a post about why we’re not going to the film fest this year. 
June 17, 2016
Book Recommendations – June, 2016
Here are a few books I’ve recently read that I’d recommend (one with reservations):
Last month I visited my parents, and my dad offered me a bunch of books that he’d read and wanted to get rid of. I started to sift through them, but then thought, “What the heck,” and said I’d take them all (much to my partner’s dismay!). They’re stacked up next to the bed, and occasionally I grab one from the stack. Except for a couple of books by Ruth Rendell, they’re all by authors I hadn’t previously read. I’ve read two books so far:
Sweet Heart by Peter James: This is the one I’d recommend with reservations. It’s about a woman who moves to a new house in the country and starts to catch glimpses of a former life. It’s a mild horror novel, but there are a few scenes in which animals are badly hurt. I don’t like to read anything that harms animals, so I glossed over those scenes. If I hadn’t been so far into the book when the first animal scene happened, I would have put the book down. Apart from the animal bits, it was an interesting read, and I’ll try the other book by him that’s on the stack.
Shock Wave by Clive Cussler: I’d never read Cussler before, and I was pleasantly surprised. I like action books. When reading them, I never expect deep topics or characters. I expect a hero (or heroine) who can get himself out of every situation no matter how dire, things blowing up, car or boat chases, over-the-top antagonists with twirly moustaches, etc. That’s exactly what Cussler delivered in this book. It starts in the past and then jumps to the present, which added an interesting dimension. I’ll definitely read the other Clive Cussler on the stack.
That’s it for the “dad” books.
Proof of Heaven by Eben Alexander: Last year I was browsing books in an actual brick and mortar bookstore, something I rarely do, and I came across this book. It’s non-fiction about a near-death experience (NDE). What’s notable about it is that it’s written by a neurosurgeon. He thought NDEs were “fantasies produced by brains under extreme stress” until he contracted meningitis and was in a coma for over a week, with no brain activity in the parts of the brain that matter when it comes to consciousness. He had an NDE, and this book is all about it.
I didn’t buy the book that day. I have a folder of books that I may want to read, and every time I need to top up an order at Amazon to get free shipping (I’m not a Prime member because I think it’s overpriced in Canada for what we get), I add a book or two from the “to buy” folder to the order. The books I choose depend on my mood at the time, and finally it was this book’s turn.
It’s an interesting book, and certainly raises a lot of questions. I doubt it will change anybody’s mind. If you believe in an afterlife going in, you’ll believe in one when you’ve finished the book. If you don’t, I doubt it’ll change your mind, but you never know. If you’re interested in this sort of stuff, it’s a worthwhile read.
My Life by Doris McCarthy: Toronto holds an annual “Doors Open” event. For one weekend in May, the public can tour buildings that are usually off limits. We go to one or two locations every year. This year, we visited Fool’s Paradise, the residence of the late Doris McCarthy, who was a Canadian artist. She died in 2010, when she was 100 years old. I have to admit that I hadn’t heard of her before, but she was quite an independent woman in a time when women were supposed to get married and have babies. Instead, she had a couple of affairs with married men and then decided she never wanted to marry because of the compromises she’d have to make. She built most of Fool’s Paradise herself, and when she bought it, it was in the boonies. Today it’s in Scarborough, but back in the thirties, there was nothing there. It’s called Fool’s Paradise because when her mother heard that she’d bought the land, she considered the purchase extravagant and referred to it as “that fool’s paradise of yours.” The name stuck.
My Life is an autobiography. If you’re interested in art, catching glimpses of Toronto history, or what it was like to be a woman in the early twentieth century (if she’d gotten married, she would have been forced to give up her teaching job, because married women didn’t need jobs, apparently) pick up the book. For information about Fool’s Paradise, go here.
I’ll conclude with a reminder that I’m currently serializing The Atheist at Wattpad. We’re up to chapter twelve now, with five chapters to go.
Enjoy your weekend! 
May 27, 2016
The Atheist is Free to Read on Wattpad

You can currently read The Atheist on Wattpad (free!). Right now, the first three chapters of the book are available. I post new story parts every Monday, Wednesday, and Friday morning.
This is all part of a special Smashwords promotion going on at Wattpad. There are about 50 mystery and thriller books included in the promotion. We all agreed to make our books available on the platform for at least three months. Some books have always been there, and maybe some authors will keep their books up for longer than the required time. I’ll be taking The Atheist down after three months.
If you haven’t read it, here’s your chance to check it out:
https://www.wattpad.com/myworks/72441797-the-deiform-fellowship-one-the-atheist
Have a great weekend! 
May 13, 2016
Mystery/Thriller Book Sale!

Today and tomorrow, there’s a mega-sale of mystery/thriller books over at Mystery and Thriller Book Promotions. Renee Pawlish is a fellow mystery writer who wanted to organize the same type of sale for mystery/thriller readers that Patty Jansen holds for science fiction and fantasy readers. Every book is on sale for 0.99. There’s a good mix of books, everything from cozy to paranormal to crime. If you’re looking for something to read over the weekend, head on over to the sale. It’s a good opportunity to try new authors at a great price.
Have a great weekend! 
April 29, 2016
New Release: Loyalty and Lies
Loyalty and Lies, the sixth installment in the Daros Chronicles, is now available. It took me a little longer than usual to release this one because I put it aside to finish Scarred Souls, but now I’m back on track. I’m already writing the seventh installment, which will end Volume One.

Loyalty and Lies
Author: Sarah Ettritch
Series: The Daros Chronicles, Book 6
Genre: Fantasy
Avere gambles with Erryn’s life, and Fi and her followers decide their next move. More info →






In other news, I’m currently running a flash sale on The Atheist. You can pick it up for free at Google Play, but only for the next couple of days. The sale ends May 1st. If you haven’t tried the Deiform Fellowship series, here’s your chance. Grab it here.
Have a great weekend! 
April 1, 2016
Does Life Have Meaning Without God?
At the end of Unseen Bonds, the third book in the Deiform Fellowship series, I asked readers to come over to my site and answer two quick questions. I was interested in how they felt about two parts of the book.
If you haven’t read the Deiform Fellowship series, there are two main characters: Jillian, who is an atheist, and Sam, who is a Christian. They have to work together, and they sometimes talk about God and religion.
In Unseen Bonds, they have quite a meaty conversation about whether life has meaning without God. Jillian argues that it does. She acknowledges that it doesn’t have eternal meaning, but it does have meaning. Sam argues that without God, life doesn’t have meaning. I was curious about where readers stood on this question.
The other question I asked concerned what one of the characters did at the end of the book. I have to be vague because I don’t want to give away the end of a mystery. If you’ve read the book, you’ll know what I’m talking about.
The poll is still open and will remain open as long as Unseen Bonds is out there. If you’ve read the book and you haven’t answered the questions, consider doing so. The link to the poll is at the end of the book.
How have readers responded so far? I’ll cover the easy question first. The majority of readers (88%) agreed with what the character did at the end of the book.
Now for the tougher question: does life have meaning without God? The poll offers the following choices:
Jillian was right – without God, life has meaning.
Sam was right – without God, life doesn’t have meaning.
They both made good points, but I mainly agree with Jillian.
They both made good points, but I mainly agree with Sam.
I can see both sides. It will depend on what day you ask me.
They were both out to lunch.
For reporting purposes, I’ve combined answers 1 and 3, and answers 2 and 4. Here’s how it breaks down so far. Things could change as more readers answer the question.
45% agree with Sam.
33% agree with Jillian.
22% say it will depend on what day they’re asked.
Nobody thought they were out to lunch. That doesn’t surprise me. I’d only expect someone to choose that option if they’re hostile toward any discussion about God and the meaning of life, but anyone who would react that way wouldn’t read Unseen Bonds. If they tried the series by reading The Atheist, they would drop it like a hot potato and vow to never read another Deiform Fellowship book again.
Anyway, where do I stand on the question of whether life has meaning without God? I agree with Sam, though I can also sympathize with those who said, “It depends on what day you ask me”. I’d venture to say that only those wearing blinders, who never, ever question their own worldview on this, wouldn’t sympathize with the “it depends” answer.
At first blush, you might think that all theists would side with Sam, and all atheists would side with Jillian. That’s not the case. While I would expect most, maybe all, theists to side with Sam, there are atheists who would also side with her and agree that if there isn’t some type of interested creator, our lives don’t have meaning.
When I’m writing the Deiform Fellowship, I always have to be careful not to impose my worldview into any conversations, and I like things to be balanced. That doesn’t mean Jillian or Sam can never “win” a discussion, but over the course of the book and series, I’d like them to stay about even, and I wanted both of them to make good arguments in this particular conversation. Because of that, I held back when writing Sam’s dialogue. If I were to have that conversation with someone in person, I’d have a lot more to say on the subject, and I’m sure the other side would, too.
There is no right or wrong answer to this question. I think that regardless of where one stands, we should treat ourselves and each other well, learn as much as we can, enjoy our lives, and read lots of books!
You can check out the first book in the Deiform Fellowship series here.
Have a great weekend. 
Does Life Have Meaning Without God? is a post from: Sarah Ettritch





February 26, 2016
Scarred Souls is Available and Other News

Scarred Souls, the fourth book in the Deiform Fellowship series, is now available. I’ve used Amazon’s new sample embed feature in this post, so you can read the sample right from this page or download it to your Kindle app. The book is also available at the other major online bookstores. You can find more information about the book here.
At the end of Unseen Bonds (Deiform Three), I asked readers to take a poll. I’ll discuss the results (so far) in an upcoming post.
The Rymellan Series is Available in Kindle Unlimited
I’ve put the Rymellan series into the Kindle Unlimited subscription program. I thought long and hard about this, because it meant taking the series down from every other store. I didn’t choose the Rymellan series willy-nilly. I analyzed my sales data from the last year, to see if any books had sold primarily on Amazon. It turned out that 95% of sales of the Rymellan series took place on Amazon, which made it the best candidate to give Kindle Unlimited a try.
Books have to remain in Kindle Unlimited for 90 days, at which point the author can keep them in for another 90 days, or remove them. I’ll see how the books do in the program.
At this time, I’m not intending to add other books to the program. Most of my other books sell enough copies off Amazon that it wouldn’t make sense to make them exclusive to Amazon. For example, in 2015, more than 85% of sales of The Missing Comatose Woman weren’t at Amazon.
The Rymellan print books are still available everywhere. The Amazon exclusivity requirement only applies to the ebook version.
Daros Chronicles
I’ve finished the first draft of Daros 6, and it’s a goodie! I can’t wait to get started on Daros 7, but I’ll polish 6 for my editor first.
Quick Poll
I asked my mailing list to take a quick, one-question poll, and now I’m asking you. If you’re on my list and haven’t taken the poll, or you’re seeing this for the first time, please add your two cents. If you’re not reading this at my site and can’t see the poll, come to the site and check it out. I’m not sure if the embed code works in email and the RSS feed.
Take Our Poll
Have a great weekend!
Scarred Souls is Available and Other News is a post from: Sarah Ettritch





February 19, 2016
Scarred Souls is Almost Here
I’ll release Scarred Souls (The Deiform Fellowship Four) next week, so I thought I’d give you a couple of teaser quotes from the book. I’m pleased with the story. It’s a great mystery, and it has some gut-wrenching personal scenes. When I was writing the first draft, I said that it would be draft version 0.9, because I wanted to go back and rewrite some of the personal stuff. I felt I could do better, and I apparently did.
My editor told me how much she enjoyed that part of the story, and so did my beta reader. I guess my instincts were right.
Look for the digital version of Scarred Souls in online bookstores next week. Print will follow in a month or two.
What’s next? Well, I’ve finished the first draft of Daros 6, so I’ll start whipping it into shape for my editor. Also, I’m going to start the standalone science fiction novel I mentioned in my first post of the year. It’ll be in the cyberpunk genre. I hope to stick with it. Last year, I started and abandoned a few projects, so there’s no guarantee that the new project will see the light of day, but I’m hopeful.
Enjoy your weekend.
Scarred Souls is Almost Here is a post from: Sarah Ettritch





February 6, 2016
Book Sale, Book Recommendations, and Other News
SF/F author Patty Jansen is having another one of her fantastic promos. This time, a bunch of $0.99 boxed sets are on offer at Amazon, including Threaded Through Time. For a very limited time (I’ll be setting the price back to normal right after the promo), you can get both books for a total of $0.99. Check out the promo here.
Threaded Through Time is a time travel story with strong romantic elements. It’s also a coming out story. I won’t be offering the boxed set at such a low price again any time soon.
The Deiform Fellowship
I’m currently proofreading the Kindle version of Scarred Souls (Deiform Fellowship Four). At this stage, I’ve already read the book many times, so I pace myself and only proofread a couple of chapters a day. If all goes to plan, I expect to release the book sometime during the week of February 22.
Daros Chronicles
I expect to finish the first draft of Daros 6 on Monday or Tuesday. However, I could only get an editing date in April, so the installment will be released in late April/early May.
Books I’ve Read
I’ve read a couple of great books lately. If you’re a fan of The Good Wife, you might want to check out Alan Cumming’s memoir Not My Father’s Son. He plays Eli Gold on the show. He’s also been in a bunch of other stuff, but I only know him from The Good Wife.
If you’re a fan of Homeland, Homeland: Carrie’s Run is a good read. I don’t often read books based on TV shows, but I really like Homeland (I’ve only watched three seasons so far. I’m waiting for the others to show up on Netflix). When I was looking for something new to read, I decided to give the novel a try. Now the other prequel novel, Homeland: Saul’s Game, is on my to-read pile.
Talk to you soon.
Book Sale, Book Recommendations, and Other News is a post from: Sarah Ettritch





January 15, 2016
Scientology: How One Person Escaped
 I’ve already read a number of great books this year, including Beyond Belief: My Secret Life Inside Scientology and My Harrowing Escape by Jenna Miscavige Hill. I’d seen a few documentaries about Scientology before, but this is the first time I’d read an ex-scientologist’s account of what it’s like to belong to the Sea Org (short for Sea Organization). The Sea Org is Scientology’s “clergy”. The most dedicated Scientologists belong to it.
I’ve already read a number of great books this year, including Beyond Belief: My Secret Life Inside Scientology and My Harrowing Escape by Jenna Miscavige Hill. I’d seen a few documentaries about Scientology before, but this is the first time I’d read an ex-scientologist’s account of what it’s like to belong to the Sea Org (short for Sea Organization). The Sea Org is Scientology’s “clergy”. The most dedicated Scientologists belong to it.
What’s doubly interesting about this book is that it’s written by the niece of David Miscavige, the current leader of the “Church”. He took over when L. Ron Hubbard died. Miscavige Hill’s parents were Scientologists, so she was indoctrinated as a child. A large part of the book is about her childhood. She writes about how little she saw of her parents, how hard children as young as six had to work (including manual labour), and how children were indoctrinated to believe Scientology’s teachings.
When Miscavige Hill was between the ages of 12 and 16, she only saw her parents three times. They left Scientology before she did and wanted to take her out of the church with them. Despite having no freedom and receiving wages of $45/week for working eighteen hour (and sometimes longer) days, she refused to leave. Looking back, she realizes that she was brainwashed (I’d prefer to use the word indoctrinated).
Before I wrote The Cult, I read Seductive Poison: A Jonestown Survivor’s Story of Life and Death in the People’s Temple, an account of life within Jim Jones’s cult by someone who was close to him and managed to escape before the mass suicide occurred. As I mentioned earlier, I’ve also seen several documentaries about cults and read other (more academically-inclined) books about them. I know cult members are indoctrinated. I have some understanding of the mindset. Still, when I read books by ex-cult members recounting the abuse, the shit they took, and the complete lack of freedom, I can’t help but think, “Why didn’t you just leave?” I immediately remind myself that indoctrination is extremely powerful, and in Miscavige Hill’s case, Scientology was the only family she knew. As she says in the book, the closest people to her were her friends. Leaving with her parents would have meant leaving the people who were most important to her behind.
Eventually she did get out, and now she speaks out against Scientology. In the book, she talks about an interview she did for ABC’s Nightline in 2008. It almost wasn’t aired. Behind the scenes, the church tried to convince her to back out by threatening to cut her and her husband off from his family (she met her husband while they were both Scientologists, and his family are public Scientologists—members who don’t belong to the Sea Org, so they don’t live and work on a Scientology base). I found the interview on YouTube.
If you’re interested in Scientology or cults, or reading about people who have turned their lives around, you’ll enjoy Miscavige Hill’s book.
Scientology: How One Person Escaped is a post from: Sarah Ettritch